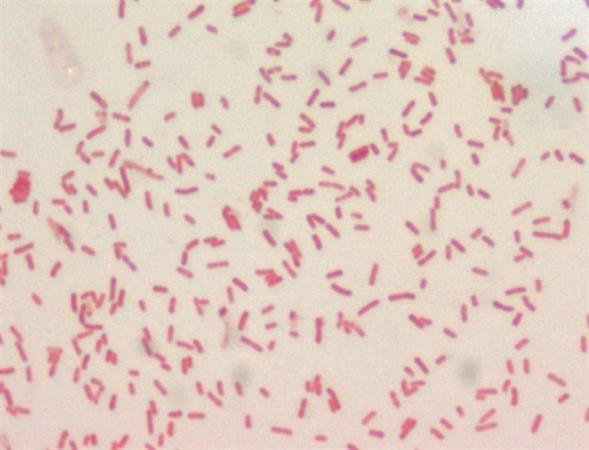
Yersinia pestis

I. Wstęp
A. Wprowadzenie do tematu
Dżuma, zwana również dżumą dymieniczą, to choroba zakaźna wywoływana przez bakterię Yersinia pestis. Bakteria ta przenoszona jest głównie przez pchły żywiące się krwią zarażonych gryzoni, takich jak szczury. Choroba może przybierać kilka form, w tym dżumę dymieniczą, dżumę płucną i dżumę septyczną.
Objawy dżumy mogą obejmować gorączkę, dreszcze, bóle ciała, obrzęk węzłów chłonnych oraz inne objawy. W historii dżuma była przyczyną wielu śmiertelnych pandemii, szczególnie w średniowieczu, lecz obecnie jej występowanie zostało ograniczone dzięki postępowi medycyny i zdolności do skutecznego leczenia i kontrolowania epidemii.
B. Znaczenie dżumy w historii
Dżuma miała ogromne znaczenie w historii, szczególnie w średniowieczu, kiedy to epidemie dżumy przynosiły setki tysięcy zgonów. Pandemia dżumy czarna w XIV wieku, znana również jako Czarna Śmierć, spowodowała śmierć około 25 milionów ludzi w Europie, co stanowiło wtedy około jedną trzecią populacji kontynentu. Można powiedzieć, że dżuma miała niebagatelny wpływ na historię Europy i całego świata, kształtując społeczeństwo, gospodarkę i kulturę.
II. Historia Dżumy
A. Początki dżumy
Pierwsze zapisane przypadki dżumy miały miejsce w starożytnych Chinach około 224 roku p.n.e. Choroba prawdopodobnie pojawiła się w dolinie rzeki Huang He. W kolejnych wiekach rozprzestrzeniła się na inne kontynenty, przyczyniając się do licznych epizodów epidemii.
B. Pandemia Justyniana (541–542)
Jedną z najpierw pandemii dżumy była tzw. pandemia Justyniana, która miała miejsce w VI wieku. Epidemia ta przyniosła śmierć milionom ludzi na Bliskim Wschodzie, w basenie Morza Śródziemnego i w innych regionach.
C. Czarna Śmierć (1347–1351)
Jednym z najtragiczniejszych wydarzeń związanych z dżumą był wybuch pandemii znanej jako Czarna Śmierć. W latach 1347–1351 ta pandemia spowodowała śmierć około 25 milionów ludzi w Europie, co stanowiło wtedy około jedną trzecią populacji kontynentu.
D. Późniejsze epidemie dżumy
Po pandemii Czarnej Śmierci, dżuma powróciła wielokrotnie, przynosząc śmierć tysiącom ludzi na różnych kontynentach. W XVII wieku miała miejsce seria epidemii w Europie, a w XVIII i XIX wieku dżuma nawiedziła Azję, Afrykę i Amerykę.
E. Dżuma w czasach nowożytnych
Obecnie, dzięki postępowi medycyny, występowanie dżumy zostało znacznie ograniczone. Istnieją jednak nadal ogniska tej choroby w niektórych częściach świata, głównie w Azji i Afryce. Dzięki odpowiednim środkom zapobiegawczym i skutecznym leczeniu, epidemie dżumy są obecnie rzadkie, ale wciąż wymagają stałej uwagi ze strony służby zdrowia i instytucji odpowiedzialnych za kontrolę chorób zakaźnych.
III. Przyczyny i Przebieg Choroby
A. Bakteria Yersinia pestis
Dżuma jest chorobą wywoływaną przez bakterię Yersinia pestis. Bakteria ta jest przenoszona przez pchły żywiące się krwią zarażonych zwierząt, takich jak szczury, które są jednym z głównych nosicieli choroby.
B. Drogi zakażenia
Najczęstszą drogą zakażenia dżumy u ludzi jest ukąszenie przez zarażoną pchłę. Bakterie Yersinia pestis mogą również być przenoszone poprzez kontakt z płynami ustrojowymi chorych lub zarażonych zwierząt.
C. Objawy kliniczne
- Dżuma dymienicza: Objawy tej postaci dżumy obejmują gorączkę, bóle mięśni, dreszcze oraz obrzęk węzłów chłonnych, które stają się bolesne i twarde. Może wystąpić również wysypka.
- Dżuma płucna: Jest rzadszą formą dżumy, ale bardziej zakaźną. Objawy dżumy płucnej obejmują gorączkę, ból głowy, kaszel z krwią, duszność i ból klatki piersiowej.
- Dżuma septyczna: Jest najbardziej groźną postacią dżumy. Objawy związane z dżumą septyczną mogą obejmować gorączkę, wymioty, biegunkę, wyniszczenie organizmu oraz zmiany skórne. Choroba może prowadzić do wstrząsu septycznego i zagrażać życiu pacjenta.
Wszystkie formy dżumy wymagają szybkiego leczenia, gdyż choroba może prowadzić do powikłań oraz zgonu, jeśli nie zostanie odpowiednio zdiagnozowana i leczona. Obecnie dostępne są skuteczne antybiotyki, które mogą pomóc w leczeniu dżumy, zwłaszcza jeśli diagnoza zostanie postawiona we wczesnym stadium choroby. Regularne szczepienia stosowane są w regionach zagrożonych, aby zapobiec wybuchom choroby. Konsekwentne zastosowanie środków zapobiegawczych oraz szybka interwencja medyczna są kluczowe w przypadku wystąpienia potencjalnych wybuchów dżumy.
IV. Diagnoza i Leczenie
A. Metody diagnostyczne
Diagnoza dżumy może być potwierdzona poprzez badanie kliniczne pacjenta oraz odpowiednie testy laboratoryjne. Testy laboratoryjne, takie jak badanie kału, moczu, krwi, plwociny czy wymazu z węzłów chłonnych, mogą potwierdzić obecność bakterii Yersinia pestis. Dodatkowo, obrazowanie medyczne, takie jak rentgen klatki piersiowej, może być pomocne w diagnostyce dżumy płucnej.
B. Tradycyjne metody leczenia
W przeszłości tradycyjne metody leczenia dżumy obejmowały izolację chorych, stosowanie ziół i innych naturalnych leków oraz zabiegi medyczne mające wspomóc leczenie objawowe. Niestety, przed erą antybiotyków, skuteczne metody leczenia dżumy były bardzo ograniczone.
C. Współczesne podejście do leczenia
Obecnie, głównym sposobem leczenia dżumy jest stosowanie antybiotyków. Szybkie rozpoznanie i wczesne podjęcie leczenia antybiotykowego są kluczowe dla skutecznego zwalczenia infekcji. W przypadku cięższych postaci dżumy, może być konieczne hospitalizacja pacjenta i podjęcie intensywnej terapii.
D. Rola antybiotyków
Antybiotyki, takie jak streptomycyna, tetracyklina czy ciprofloksacyna, są skutecznymi lekami w walce z bakterią Yersinia pestis. Szybkie rozpoczęcie antybiotykoterapii może pomóc w ograniczeniu powikłań i zapobiec dalszemu rozprzestrzenianiu się choroby. Istnieje również profilaktyczne stosowanie antybiotyków u osób narażonych na zakażenie dżumą.
Współczesne podejście do diagnostyki i leczenia dżumy opiera się na szybkiej identyfikacji choroby, stosowaniu antybiotyków oraz odpowiednich środków kontroli zakażeń, takich jak izolacja chorych i śledzenie kontaktów. Regularne monitorowanie i reagowanie na potencjalne ogniska dżumy są kluczowe dla zapobiegania rozprzestrzenianiu się tej groźnej choroby.
V. Epidemiologia Dżumy
A. Geograficzne rozprzestrzenienie
- Dżuma występuje głównie w rejonach Azji, Afryki i Ameryki Łacińskiej, zwłaszcza w obszarach wiejskich i miejskich, gdzie istnieje bliski kontakt między ludźmi a gryzoniami.
- Historycznie, dżuma była szeroko rozpowszechniona w Europie i Azji, jednak obecnie wykazuje się głównie w pewnych obszarach świata.
B. Wpływ warunków klimatycznych
Warunki klimatyczne, zwłaszcza ciepłe i wilgotne, sprzyjają rozprzestrzenianiu się dżumy, ponieważ sprzyjają one rozwojowi pcheł i innych wektorów przenoszących bakterię Yersinia pestis.
C. Rezerwuar zwierzęcy
Gryzonie, zwłaszcza szczury, stanowią główny rezerwuar dżumy. Bakteria Yersinia pestis może być przenoszona przez pchły, które żywią się krwią zainfekowanych zwierząt. Ludzie mogą zarazić się dżumą poprzez kontakt z zainfekowanymi gryzoniami, ich odchodami lub zaatakowanie przez zarażone pchły.
D. Czynniki ryzyka
Czynniki ryzyka zakażenia dżumą obejmują niewłaściwe warunki sanitarne, brak higieny osobistej, obecność dużych populacji gryzoni, niewystarczające środki przeciwko pchłom oraz przebywanie w obszarach endemicznych dla dżumy. Przypadki dżumy były również obserwowane u pracowników służb zdrowia, którzy mieli kontakt z zakażonymi pacjentami.
Epidemiologia dżumy zmieniała się w ciągu historycznie obserwowanych epizootii i epidemii. Obecnie, mimo obecności antybiotyków i możliwości kontroli populacji gryzoni, dżuma nadal stanowi zagrożenie dla ludzi, zwłaszcza w obszarach o niskim poziomie sanitarnym i higieny, oraz może wywoływać lokalne epidemie. Regularne monitorowanie obecności dżumy u gryzoni oraz edukacja dotycząca efektywnych praktyk prewencyjnych są kluczowe dla ograniczenia ryzyka związanego z tą chorobą.
VI. Społeczno-Ekonomiczne Wpływy Dżumy
A. Wpływ na społeczeństwo
Dżuma ma poważny wpływ na społeczeństwo, zarówno pod względem zdrowia publicznego, jak i społeczności. Epidemie dżumy mogą prowadzić do paniki, strachu i dezinformacji w społecznościach dotkniętych chorobą. Może to prowadzić do izolacji zarażonych osób, stigmatyzacji oraz utraty zaufania i spójności społecznej. Jednocześnie działania podejmowane w celu kontrolowania epidemii, takie jak izolacja chorych czy kwarantanna, mogą dodatkowo wpływać na społeczności lokalne.
B. Zmiany demograficzne
Epidemie dżumy mogą wywołać znaczące zmiany demograficzne w społecznościach dotkniętych chorobą. Wysoka śmiertelność spowodowana dżumą może prowadzić do zmniejszenia liczby ludności w danej społeczności, szczególnie jeśli nie zostanie podjęte skuteczne działanie w celu kontrolowania epidemii.
C. Skutki ekonomiczne
Dżuma ma także istotne skutki ekonomiczne. Epidemie dżumy mogą prowadzić do upadku lokalnych gospodarek, szczególnie w obszarach wiejskich, gdzie rolnictwo i handel mogą zostać mocno dotknięte chorobą. Dodatkowo, koszty związane z leczeniem chorych, zwiększeniem działań prewencyjnych oraz straty w produkcji mogą znacząco wpłynąć na sytuację ekonomiczną danej społeczności.
D. Przemiany kulturowe
Epidemie dżumy mogą również wywołać przemiany kulturowe w społecznościach dotkniętych chorobą. W rezultacie pandemii, pewne praktyki kulturowe lub religijne mogą ulec zmianie, aby dostosować się do nowej rzeczywistości związanej z dżumą. Ponadto, długotrwałe skutki dżumy mogą mieć wpływ na sposoby myślenia, postawy społeczne oraz relacje międzyludzkie w danej społeczności.
Rozważając te aspekty, ważne jest, aby podejmować działania nie tylko w celu kontrolowania epidemii dżumy, ale także w celu wsparcia społeczności dotkniętych chorobą i minimalizowania jej społeczno-ekonomicznych skutków. Współpraca między instytucjami zdrowia publicznego, społecznością lokalną i władzami, może pomóc w efektywnym zarządzaniu sytuacją związaną z dżumą.
VII. Dżuma w Kulturze i Literaturze
A. Dżuma w literaturze
- „Dżuma” Alberta Camusa: „Dżuma” to powieść napisana przez francuskiego pisarza i filozofa Alberta Camusa. Jest to jedno z najbardziej znaczących dzieł literatury XX wieku, które porusza temat epidemii dżumy w mieście Oran. Camus wykorzystał tę historię do ukazania reakcji ludzi na zagrożenie i cierpienie, a także do analizy zachowań, morale oraz kondycji ludzkiej w obliczu tragedii. Powieść „Dżuma” jest uważana za ważne dzieło literackie, które w sposób symboliczny odnosi się do różnych aspektów ludzkiego doświadczenia w obliczu tragedii i choroby.
B. Dżuma w sztuce
Temat dżumy często pojawia się również w sztuce, zarówno współczesnej, jak i historycznej. Często jest on wykorzystywany jako metafora dla różnych form zła, cierpienia czy zagrożenia. Obrazy, rzeźby czy instalacje artystyczne odnoszące się do dżumy mogą ukazywać jej wpływ na społeczeństwo, jednostki czy ludzką psychikę.
C. Dżuma w muzyce
Chociaż nie jest to tak powszechne jak w literaturze czy sztuce, temat dżumy pojawił się również w niektórych dziełach muzycznych. Niektóre kompozycje muzyczne odnoszą się do dżumy jako sposobu na wyrażenie emocji, strachu czy dramatu związanych z epidemią. Teksty utworów muzycznych mogą opowiadać historie dotkniętych chorobą osób, reakcji społeczności lub refleksji na temat natury ludzkiej i życia w obliczu śmierci.
Poprzez literaturę, sztukę i muzykę temat dżumy jest przedstawiany w różny sposób, co pozwala na głębsze zrozumienie ludzkiego doświadczenia oraz refleksję nad kondycją ludzką w obliczu tragedii i choroby.
VIII. Walka z Epidemiami
A. Średniowieczne metody zapobiegania
W okresie średniowiecza ludzie stosowali różnorodne metody zapobiegania epidemii, zwłaszcza dżumie. Należały do nich izolacja chorych, kwarantanna oraz stosowanie zdrowego stylu życia, w tym dbanie o higienę i czystość. W niektórych przypadkach podejmowano także działania mające na celu oczyszczenie powietrza, na przykład poprzez spalanie ziół czy substancji zapachowych.
B. Rozwój medycyny i higieny
W miarę postępu nauki i medycyny, metody zapobiegania epidemii, w tym dżumy, ulegały ewolucji. Odkrycia medyczne, szczególnie z dziedziny bakteriologii i immunologii, umożliwiły lepsze zrozumienie przyczyn i mechanizmów szerzenia się chorób zakaźnych. Również poprawa warunków sanitarnych oraz propagowanie higieny osobistej odegrały istotną rolę w redukcji ryzyka wystąpienia epidemii.
C. Szczepienia
Jednym z najskuteczniejszych sposobów walki z epidemią jest szczepienie populacji przeciwko chorobom zakaźnym. Dzięki przeprowadzanym programom szczepień udało się wyeliminować lub znacząco ograniczyć rozprzestrzenianie się takich chorób jak ospa prawdziwa czy polio. Szczepienia stanowią kluczowy element strategii zapobiegania epidemii i są jednym z najskuteczniejszych narzędzi ochrony zdrowia publicznego.
D. Współczesne strategie kontroli epidemii
- Obecnie walka z epidemią opiera się na zintegrowanych strategiach, które uwzględniają zarówno aspekty medyczne, jak i społeczne.
- Współczesne strategie kontroli epidemii obejmują
- monitoring chorób zakaźnych,
- szybką identyfikację przypadków,
- kwarantannę,
- śledzenie kontaktów zakażonych,
- edukację społeczeństwa
- oraz stosowanie środków prewencyjnych, takich jak noszenie maseczek czy dezynfekcja rąk.
- Ważnym elementem kontroli epidemii jest również współpraca międzynarodowa i wymiana informacji oraz doświadczeń pomiędzy krajami.
Poprzez stosowanie zróżnicowanych metod, rozwoju medycyny i higieny, szczepień oraz nowoczesnych strategii kontrolnych, ludzkość podejmuje działania mające na celu zapobieganie epidemii i ochronę zdrowia publicznego.
IX. Nauki z Historii Dżumy
A. Znaczenie badań historycznych
Badania historyczne nad dżumą mają istotne znaczenie dla zrozumienia sposobu, w jaki ludzkość radziła sobie z epidemią w przeszłości. Dziedzictwo dżumy pozwala na lepsze zrozumienie szerszych kontekstów społecznych, ekonomicznych i kulturowych, które miały miejsce w okresach epidemii. Historia dżumy uświadamia, jak istotne jest stosowanie wiedzy historycznej do tworzenia strategii walki z chorobami zakaźnymi oraz podejścia do zdrowia publicznego.
B. Zastosowanie zdobytej wiedzy
- Wiedza z zakresu historii dżumy przyczyniła się do rozwoju dziedziny naukowej zwaną epidemiologią historyczną.
- Badania nad dżumą oraz innymi historycznymi epidemiami pomagają naukowcom lepiej rozumieć mechanizmy rozprzestrzeniania się chorób, ich wpływ na społeczeństwo oraz skuteczność różnych strategii zwalczania epidemii.
- Ta wiedza jest niezwykle cenna w kontekście przygotowywania się do potencjalnych przyszłych pandemii i definiowania strategii działań publicznych w zakresie zdrowia.
C. Przyszłe wyzwania
Dziedzictwo dżumy stanowi punkt odniesienia dla dzisiejszych wyzwań związanych z chorobami zakaźnymi. Przyszłość niesie ze sobą potencjalne zagrożenia związane z nowymi patogenami, odpornością na antybiotyki, a także zmianami klimatycznymi i migracją ludności, które mogą wpływać na rozprzestrzenianie się chorób. Wykorzystanie wiedzy historycznej pozwoli na lepsze przygotowanie się do przyszłych pandemii i zdefiniowanie strategii zapobiegania oraz reagowania na epidemie.
Badania historyczne nad dżumą przynoszą więc nie tylko zrozumienie przeszłych wydarzeń, ale również stanowią cenny zasób wiedzy, który może być wykorzystany do tworzenia skutecznych strategii walki z nowymi zagrożeniami zdrowotnymi.
X. Podsumowanie
A. Kluczowe wnioski
- Badania nad dżumą przynoszą wiele kluczowych wniosków dotyczących zarówno samej choroby, jak i sposobu, w jaki ludzkość radziła sobie z nią.
- Zrozumienie historii dżumy pozwala na identyfikację kluczowych czynników wpływających na rozprzestrzenianie się epidemii, stosowane metody leczenia oraz skuteczną strategię zapobiegania kolejnym przypadkom.
- Wnioski te są niezwykle cenne w kontekście walki z nowymi chorobami zakaźnymi i stanowią ważną lekcję z historii, którą warto wykorzystać w sytuacjach kryzysowych.
B. Znaczenie dżumy w historii medycyny
- Dżuma ma ogromne znaczenie w historii medycyny jako jedno z najbardziej śmiertelnych i powszechnie znanych zagrożeń zdrowotnych.
- Historia dżumy przyczyniła się do rozwoju medycyny jako dziedziny naukowej, zmuszając lekarzy i naukowców do poszukiwania skutecznych metod leczenia oraz prewencji epidemii.
- Ponadto, różne epizody dżumy pomogły w rozwinięciu teorii epidemiologicznych i zrozumienia mechanizmów rozprzestrzeniania się chorób, co ma kluczowe znaczenia również w dzisiejszych czasach.
C. Perspektywy na przyszłość
- Mimo że dżuma została opanowana dzięki postępowi medycyny i higieny, perspektywy na przyszłość wciąż zawierają potencjalne zagrożenia związane z powrotem tej choroby lub wystąpieniem nowych patogenów.
- Wnioski wyciągnięte z historii dżumy mogą pomóc w przygotowaniu się do ewentualnych przyszłych epidemii, definiowaniu skutecznych strategii działania oraz zwiększeniu świadomości społecznej na temat zagrożeń zdrowotnych.
- Perspektywy na przyszłość wymagają ciągłego rozwoju w dziedzinie medycyny, epidemiologii i zdrowia publicznego w celu skutecznego radzenia sobie z potencjalnymi zagrożeniami zdrowotnymi.
Podsumowując, dżuma jako choroba ma nie tylko ważne historyczne znaczenie, ale także stanowi lekcję, z której możemy wyciągnąć cenne wnioski i przekształcić je w skuteczne strategie działania na przyszłość.
XI. Najczęściej Zadawane Pytania (FAQ)
A. Czy dżuma wciąż stanowi zagrożenie?
Dżuma nadal stanowi zagrożenie dla niektórych obszarów świata, zwłaszcza tam, gdzie występują warunki sprzyjające rozprzestrzenianiu się bakterii Yersinia pestis. Chociaż liczba przypadków dżumy jest obecnie stosunkowo niewielka, zwłaszcza w porównaniu z historycznymi epidemiami, to kontynuacja środków prewencyjnych i monitorowania stanowi kluczowe narzędzia w kontrolowaniu zagrożenia.
B. Jakie są pierwsze objawy dżumy?
Typowe objawy dżumy obejmują gwałtowny początek gorączki, bóle głowy, nudności, wymioty oraz obrzęk okolic chorych węzłów chłonnych. Istnieje również odmiana z zapaleniem płuc, w której objawami są kaszel, duszności i bóle klatki piersiowej. W przypadku podejrzenia zakażenia dżumą, ważne jest jak najszybsze skonsultowanie się z lekarzem.
C. Czy istnieje skuteczna szczepionka na dżumę?
Tak, istnieje szczepionka przeciwko dżumie, która może zapewnić ochronę przeciwko zakażeniu. Szczepionka ta jest powszechnie używana w obszarach, gdzie dżuma nadal stanowi zagrożenie. Pomimo tego, że szczepionka jest skuteczna, to jednak nie zapewnia całkowitej ochrony, dlatego też inne środki prewencyjne, takie jak unikanie ekspozycji na pchły lub szczury, są również istotne.
D. Jakie są najskuteczniejsze metody zapobiegania dżumie?
Najskuteczniejsze metody zapobiegania dżumie obejmują kontrolę populacji szczurów i pcheł, unikanie kontaktu z dzikimi gryzoniami, stosowanie środków owadobójczych oraz szybkie leczenie osób podejrzanych o zakażenie. Dodatkowo, edukacja na temat higieny osobistej oraz świadomość zagrożeń związanych z dżumą również odgrywają istotną rolę w zapobieganiu chorobie.
E. Czy można całkowicie wyeliminować dżumę?
Istnieje dążenie do eliminacji dżumy jako publicznego zagrożenia zdrowotnego, ale całkowite wyeliminowanie choroby może być trudne ze względu na obecność naturalnych ognisk zakażeń oraz potencjalne zagrożenia ze strony nowych szczepów bakterii Yersinia pestis. Jednakże, poprzez skuteczne programy monitorowania, leczenia, szczepień oraz prewencji, możliwe jest utrzymanie choroby pod kontrolą i minimalizowanie jej wpływu na społeczność.
